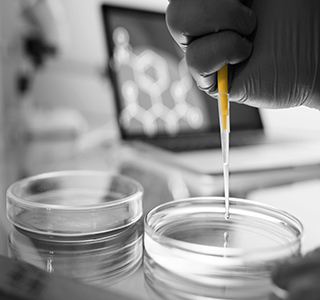

Somos un laboratorio clínico comprometido en brindar resultados oportunos y confiables que apoyan al diagnóstico, seguimiento y prevención de enfermedades, logrando contribuir con la salud de las personas a través del profesionalismo de nuestros colaboradores.